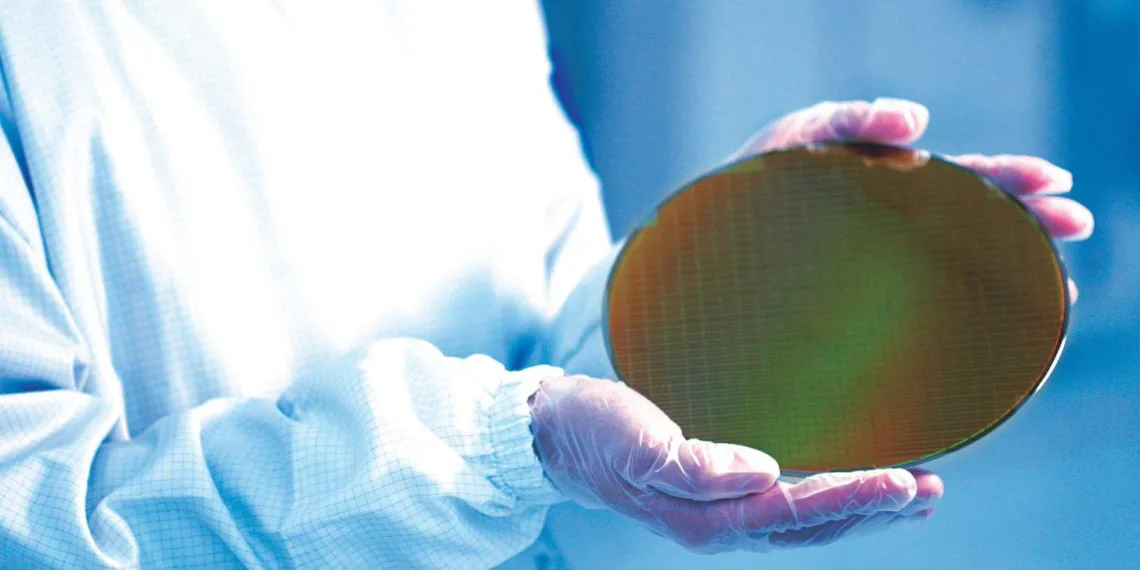

Huge news just dropped in the tech world. Samsung announced a dramatic cut to its chip manufacturing investment. The Korean tech giant is halving its budget from 10 trillion won to 5 trillion won for 2025, according to Business Korea’s latest report.
Table of Contents
Strategic Shift in Focus
Samsung’s bold decision marks a pivotal change in strategy. Rather than expanding current 5-nanometer chip production, the company’s zeroing in on next-generation 2-nanometer and 1.4-nanometer manufacturing processes. This shift comes as 2025 ushers in the era of 2-nanometer chip fabrication.
Production Challenges Drive Decision
Behind this massive cut lies a story of manufacturing struggles. Samsung’s been grappling with yield issues – a critical metric in chip production. Despite leading the pack with 3-nanometer chip announcements in 2022, including a notable shipment to a Chinese cryptocurrency mining firm, consistent production has proved challenging.

Investment Allocation
The reduced budget targets three key facilities:
Hwaeseong Plant
Currently producing 3-nanometer chips, this facility will transition to 2-nanometer production. Recent reports indicate quality issues have impacted output, making this upgrade crucial for future success.
Pyeongtaek Facility
This plant stands at the forefront of Samsung’s future, focusing on 1.4-nanometer chip development. Plans include a test production run of 3,000 wafers monthly – a modest but significant step into next-generation technology.
Taylor, Texas Site
Samsung continues investing in its American presence, allocating funds to this strategic location despite overall budget cuts.
This decision comes at a curious time. While AI-driven demand soars, with companies like NVIDIA hungry for advanced chips, Samsung’s pulling back. This move potentially hands market share to TSMC, the world’s leading contract chip manufacturer.
Technical Approaches
Both major players are taking distinct paths in 2-nanometer development:
- Samsung: Implementing gate-all-around (GAA) architecture
- TSMC: Utilizing nano sheet transistors
These different approaches aim to enhance efficiency and reduce power leakage.
Consumer Technology Impact
The ripple effects extend to major tech brands. Apple, a significant consumer of 3-nanometer chips for its devices, along with Qualcomm and other smartphone manufacturers, rely heavily on these advanced manufacturing processes.
Industry Implications
Samsung’s decision raises questions about the semiconductor industry’s future. While the company focuses on quality and next-generation technology, competitors might seize the opportunity to expand their market presence.
Looking Forward
As 2025 progresses, this strategic pivot could reshape the semiconductor landscape. Samsung’s betting that perfecting next-generation technology trumps maintaining current production levels.
This isn’t merely a cost-cutting measure – it’s a calculated gamble on the future of chip manufacturing. While the industry rushes to meet current demand, Samsung’s taking a step back to focus on tomorrow’s technology.
Market observers and industry experts continue monitoring this developing situation, as its implications stretch far beyond Samsung’s bottom line. The success or failure of this strategy could influence the entire semiconductor industry’s direction for years to come.
Got thoughts on this big move? Think they’re being brilliant or making a huge mistake? Drop your take below – this story’s far from over!
FAQs
What is Samsung’s new investment plan?
Samsung Electronics is reducing its semiconductor manufacturing investment from 10 trillion won to 5 trillion won for fiscal year 2025.
How many chips will the Pyeongtaek plant produce?
Plans call for 3,000 1.4-nanometer wafers monthly during test production.